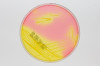

Intended purpose of the test:
eazyplex® MRSAplus is a manual in vitro diagnostic medical device for the qualitative detection of specific nucleic acid sequences (DNA) of MRSA (methicillin-resistant Staphylococcus aureus) and the Panton-Valentine Leukocidin gene (PVL) by means of the Loop-mediated isothermal amplification (LAMP) technique, from bacterial colonies of agar plates of patients with suspected Staphylococcus aureaus infection. eazyplex® MRSAplus is an aid to the diagnosis of MRSA and should not be used as the sole criterion for diagnosis.
Protective mechanisms which prevent the use of false results:
- Perfomance of an "inhibition control" with each sample prevents the use of false negative test results due to inhibition of the amplification reaction whilst simultaneously serving as a reagent control.
- The test result is only displayed if the inhibition control is valid.
- As required, a test strip can be processed as "negative/ contamination control" by testing RALF without addition of sample material. In this case, only the inhibition control is allowed to create a positive signal.